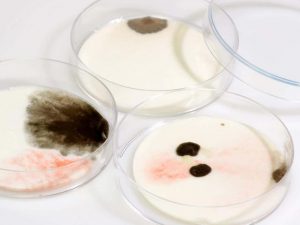

Dishwasher works with water to clean your dishes which is in the ranges of 120 degrees Fahrenheit minimum to 150 degrees Fahrenheit at max. Different kind of mold can build their home on your plates. Most of the mold can easily live in a temperature of 120 degrees Fahrenheit. Besides, some of them can even withstand more than the maximum temperature limit for a dishwasher. So, it is not a wise decision from your side if you want your dishwasher to kill the mold of your dishwasher. It will be better for you to keep in check the dishes so that it does not get the mold.
Can mold grow inside your dishwasher?
You may think that your dishwasher is clean and mold can’t grow there while the actual story is totally different. Dishwasher is washing dirty dishes and all the detergent that has been of no use when it comes to killing the mold. They don’t have the ability to get rid of these allergic and dangerous molds. Some of them can grow on the drain-pipe while others will choose the leftover food side. They are very dangerous for your children and you too. When you wash any dirty dishes then usually it left many small food particles inside the dishwasher.
As time passes, the moisture and dark environment makes them a perfect place for the growth of mold. Any leakage on the dishwasher can also be the reason for this mold problem. The clean dishes that you are seeing can be full of harmful mold. You can’t see them because they are in the micro-size. You need to get rid of them as soon as possible because they are like a boom for your good health. They can trigger harmful diseases anytime. How you can get rid of this is discussed below.
How you can kill the mold?
People used to use bleach for mold cleaning. But the truth is it can only clean the upper surface of the mold but the root of the mold keeps on living. The best past for mold cleaning is the baking soda and vinegar. You just need to add a small amount of baking soda to a cup of vinegar until it forms a past which is foamy. Perfect use of this mixture can easily eliminate 99% of the mold growth. It is a perfect cleaning agent for both dishwashers and dishes. See dishwasher safety guidelines